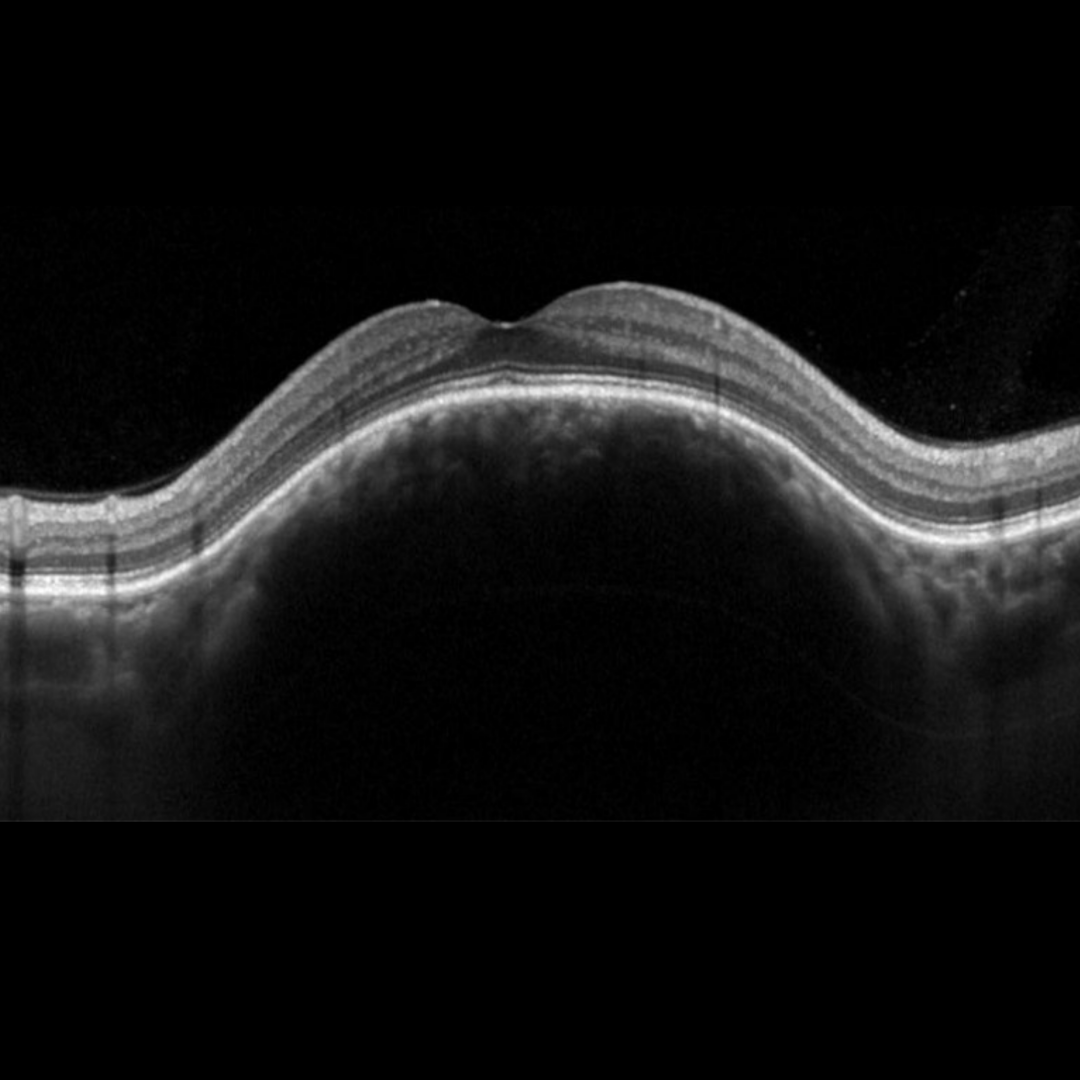

Overview
Choroidal hemangiomas are benign vascular hamartomas of the choroid. They may be either circumscribed (no systemic associations) or diffuse (often associated with Sturge Weber syndrome).
Clinically, a circumscribed choroidal hemangioma appears as orange-red elevated lesion, typically found posterior to the equator. They usually appear in isolation and are unilateral. Although considered benign lesions, overlying subretinal fluid, serous retinal detachment and cystoid macular edema are relatively common findings and may require treatment.
Lesions typically remain stable in size, however slow progressive enlargement has also been reported.
Case Example
-
Case 1
A 60-year-old Caucasian female with best corrected visual acuity of 6/6-1 (20/20-1) in the right eye. Her optometrist noted a significant hyperopic shift in the right eye approximately 25 years ago which was diagnosed as a choroidal haemangioma by an ophthalmologist. The left eye was unremarkable so this case will focus on the right eye only.
Fundus photograph (1), green-free image (2) and red-free image (3)
More infoStereoscopic view of the macula (right eye)
More infoOptomap widefield image and fundus autofluorescence image (right eye)
More infoSpectralis OCT line scans (right macula)
More infoSpectralis OCT radial macular scan (right eye)
More infoCirrus macular thickness map
More infoB-Scan ultrasound (right eye)
More info
Differential Diagnosis
References
Karimi, S., Nourinia, R., & Mashayekhi, A. (2015). Circumscribed Choroidal Hemangioma. Journal of ophthalmic & vision research, 10(3), 320–328. https://doi.org/10.4103/2008-322X.170353
Krohn J, Rishi P, Frøystein T, et al (2019) Circumscribed choroidal haemangioma: clinical and topographical features. British Journal of Ophthalmology 103:1448-1452.